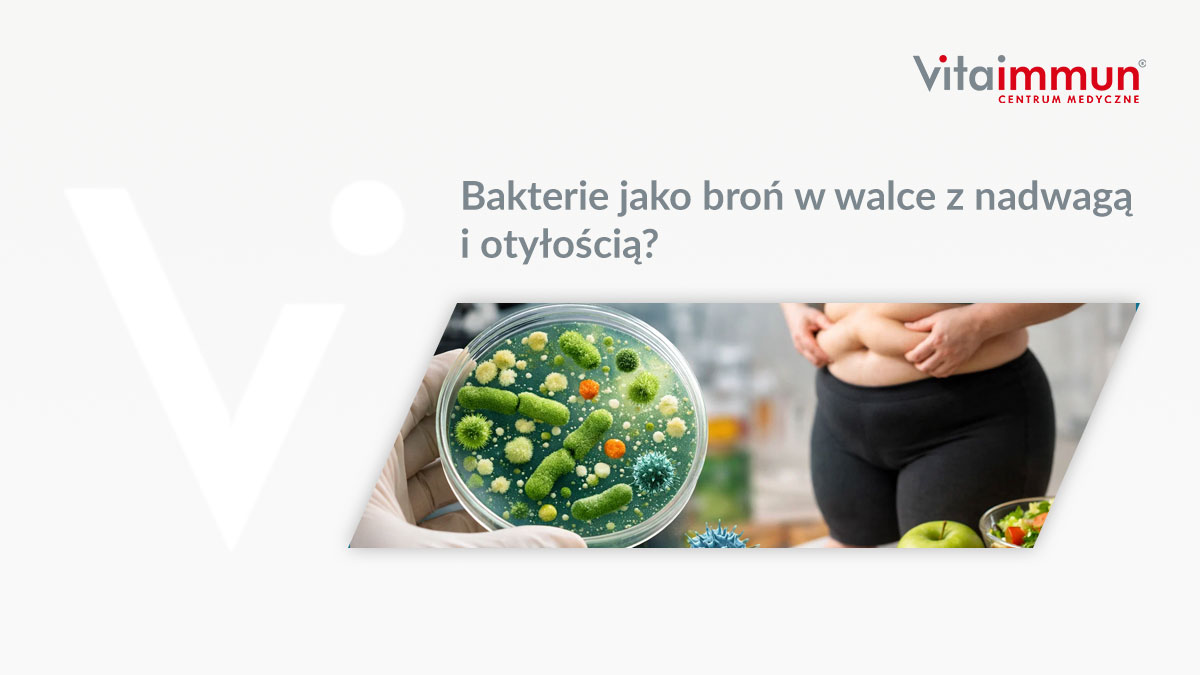
Bakterie jako broń w walce z nadwagą i otyłością?

Vitaimmun
Po co nam błonnik w diecie?
Skoro włókna pokarmowe nie ulegają one trawieniu w naszym przewodzie pokarmowym, po co nam więc ten element diety? W niniejszym artyku...
Bakterie jako broń w walce z nadwagą i otyłością?
Nadwagę i otyłość w tym momencie traktuje się jako poważny, globalny problem zdrowotny, który stanowi główny czynnik ryzyka schorzeń ta...
Alergia wziewna – co to jest?
Alergia wziewna (a właściwie każda reakcja alergiczna) to nieprawidłowa i nadmierna reakcja naszego organizmu na czynniki środowiskowe,...
Zespół metaboliczny – co to jest, jakie są przyczyny, objawy i leczenie?
Zespół metaboliczny jest złożonym zbiorem czynników ryzyka, związanych z otyłością, nieprawidłowym metabolizmem glukozy, nadciśnieniem ...
Łuszczyca – czy problem może leżeć w jelitach?
Łuszczyca, schorzenie skóry, od dawna stanowi zagadkę. Jednak ostatnie badania sugerują, że istnieje powiązanie między zdrowiem jelit a...
Depresja a problemy z jelitami – czy są ze sobą powiązane?
Obecnie szacuje się, że około 30% pacjentów zgłasza się do podstawowej opieki zdrowotnej z powodu różnorodnych zaburzeń psychicznych. P...
Nadwaga a problemy z jelitami – czy mają związek?
Nadwaga stanowi coraz poważniejszy problem zdrowotny na całym świecie, jednak jego wpływ na nasze ciało jest znacznie bardziej złożony,...
Jakie są objawy pasożytów w jelitach?
W ludzkim organizmie może przebywać nawet 300 gatunków pasożytów. Co więcej, można odkryć w każdej części naszego ciała. Żyją one w skó...